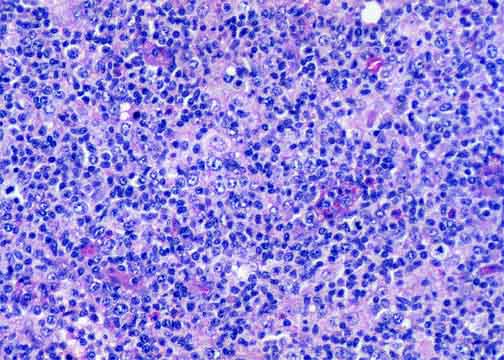
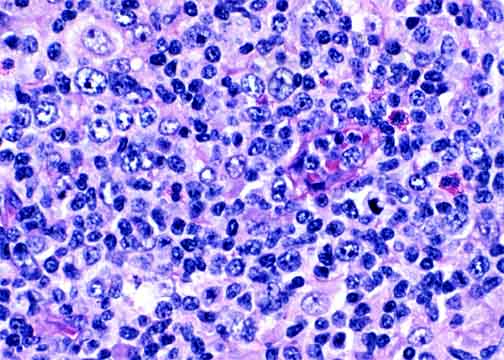

Go to:

TOC
|
Peripheral T-Cell Lymphomas: Example 3B
This is a good example of a PTCL-NOC with both small and large cells. The patient had
eosinophilia and systemic symptoms including pruritis. Note the
progression from the patient's earlier skin specimen.

The infiltrate in this lymph node is diffuse with mottling.
|
Small and large cells are mixed together.
|
The large cells here have oval, not convoluted, nuclei and moderate amounts
of pale to clear cytoplasm.
|
Table of Contents
|